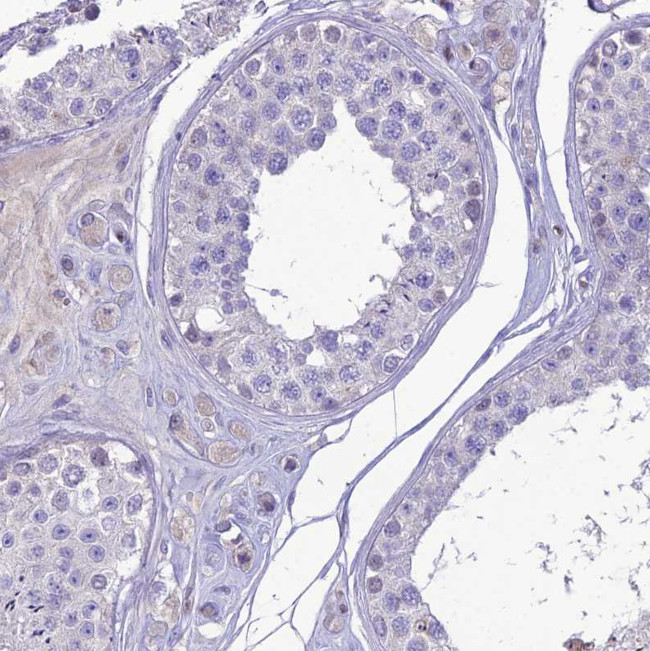
Nova-2 Antibody in Immunohistochemistry (Paraffin) (IHC (P))

Search
Invitrogen
Nova-2 Polyclonal Antibody
{{$productOrderCtrl.translations['antibody.pdp.commerceCard.promotion.promotions']}}
{{$productOrderCtrl.translations['antibody.pdp.commerceCard.promotion.viewpromo']}}
{{$productOrderCtrl.translations['antibody.pdp.commerceCard.promotion.promocode']}}: {{promo.promoCode}} {{promo.promoTitle}} {{promo.promoDescription}}. {{$productOrderCtrl.translations['antibody.pdp.commerceCard.promotion.learnmore']}}
产品信息
PA5-83784
种属反应
已发表种属
宿主/亚型
分类
类型
抗原
偶联物
形式
浓度
规格
纯化类型
保存液
内含物
保存条件
运输条件
RRID
产品详细信息
Immunogen sequence: GFLTAEKLAA ESAKELVEIA VPE
Highest antigen sequence indentity to the following orthologs: Rat - 100%, Mouse - 100%.
靶标信息
Paraneoplastic opsoclonus myoclonus ataxia (POMA) is a neurologic disorder thought to be mediated by an autoimmune attack against onconeural disease antigens that are expressed by gynecologic or lung tumors and by neurons. Nova-1 and -2 are both POMA disease antigens. The autoimmune attack against Nova-2 in POMA patients results in latent cancer, reduced inhibitory control of movements, and dementia. Nova-2 is closely related to Nova-1, and is expressed at high levels in neurons during development and at lower levels in the adult lung. In the postnatal mouse brain, Nova-2 is expressed in a pattern that is largely reciprocal with Nova-1, including high levels of Nova-2 expression in the neocortex and hippocampus. Both Novas are RNA binding proteins, and Nova-2 binds RNA with high affinity and with sequence specificity that differs from Nova-1. They regulate neuronal pre-messenger RNA splicing by directly binding to RNA. Nova-2 target genes function either in the synapse or in axon guidance indicating that Nova-2 is a major regulator of synaptic function.
仅用于科研。不用于诊断过程。未经明确授权不得转售。
生物信息学
蛋白别名: Astrocytic NOVA1-like RNA-binding protein; encodes KH-domain; Neuro-oncological ventral antigen 2; neuro-oncological ventral antigen 3; neuronal KH-type RNA-binding protein; RNA-binding protein Nova-2
基因别名: ANOVA; NEDASB; NOVA-2; NOVA2; NOVA3
UniProt ID: (Human) Q9UNW9
Entrez Gene ID: (Human) 4858